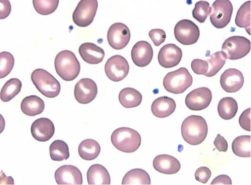

|
| Laboratórium | Segédlet a laboreredmények értékeléséhez
|
Ozmotikus Rezisztencia (OR)
Mit jelent a vörösvérsejtek ozmotikus rezisztenciája?
A vörösvérsejtek ozmotikus rezisztenciája (vagy angolszász terminussal "osmotic fragility", azaz ozmotikus törékenység) azt jelenti, hogy a vörösvérsejtek egy bizonyos szintig tolerálni tudják környezet ozmotikus nyomásának csökkenését anélkül, hogy sejthártyájuk átlyukadna, majd szétrepedne. A rezisztencia elsősorban a vörösvérsejtek térfogatától függ, miszerint minél kisebbek a sejtek, annál kisebb a membránjuk felülete, tehát annál kevésbé lesznek képesek az amúgy is korlátozott tágulásra. A környezeti ozmotikus nyomáscsökkenés hatására víz áramlik be a sejtekbe, növelve a belső nyomást. Elérve a kritikus belső nyomást először hemoglobin kezd kiáramolni a sejtekből, majd a további külső nyomáscsökkenés hatására a v.v.s.-ek megrepednek. A másik tényező, ami befolyásolja az OR-t, a membránra ható károsító hatások. Ezek lehetnek veleszületett vörösvérsejtképzési zavarok, vagy szerzett membránkárosító tényezők.
Mikor érdemes OR-t mérni?
- anaemiák esetében (különösen immun-mediált hemolytikus anaemia gyanújánál)
- veleszületett vörösvérsejtképzési anomáliák gyanúja esetén.
Milyen minta szükséges a vizsgálathoz?
Egy lila kupakos, azaz EDTA tartalmú csőbe 1-2 ml a vénást vért kell gyűjteni.
Mennyi ideig stabil a minta a meghatározáshoz?
Hűtőben néhány óráig.
Hogyan végezzük a mérést?
Pufferolt NaCl oldatból 0 és 0,9% közötti hígítási sort készítünk, 0,05%-os lépésenként. Minden hígításból 2 ml-t kémcsövekbe mérünk és hozzácseppentünk 2-2 csepp teljes vért és nagyon óvatosan összeforgatjuk. Néhány perces inkubáció után ismét óvatosan átforgatjuk a csöveket, majd centrifugáljuk és a felülúszót fotometráljuk, megállapítva a hemoglobin tartalmukat. Ezután a felülúszók Hb tartalmát százalékba fejezzük ki a teljes hemolízis értékének függvényében. A normálértéket megadhatjuk a kezdeti vagy a teljes hemolízisnek megfelelő NaCl koncentráció értékében. (1. kép)

1. kép
|
|
kezdődő hemolízis |
teljes hemolízis |
| Kutya |
0,45-0,50 |
0,35-0,40 |
| Macska |
0,65-0,70 |
0,45-0,50 |
A macska kisebb OR-ja a fajra jellemző kisebb vörösvérsejt térfogatból adódik.
|
|
Mi befolyásolhatja az OR értékét?
- a lipaemia növeli a vörösvérsejtek sérülékenységét.
- a reticulocyták ozmotikus rezisztenciája nagyobb, mint az érett vörösvérsejteké.
- a leptocyták (target sejtek) ellenállása és tágulékonysága fokozottabb.
- az eleve hemolizált vér bizonytalanná teszi az értékelést
Az OR teszt értékelése:
A csökkent OR oka lehet veleszületett vörösvérsejtképzési zavar ( veleszületett spherocytosis golden retriever kutyákban, öröklődő stomatocytosis (2. kép)
alaszkai malamut , törpe schnauzer, közép schnauzer és pomerániai kutyákban, valamint csökkent OR abesszin és szomáli macskákban).
A szerzett OR csökkenés leggyakoribb oka az immun-mediált hemolytikus anaemia (AIHA vagy IMHA).
Itt a rezisztencia csökkenés a fokozott spherocyta képződés (kisebb, egyneműen eozinofilen festődő sejtek: 3. kép)
és a membrán antigén-ellananyag reakció miatti sérülésének következménye. Hasonlóan membránkárosító a hemotróf mycoplasma
( M. haemofelis: 4. kép, M. haemocanis: 5. kép) fertőzés, ritkán krónikus azotaemia következtében is sérülhetnek a sejthártyák.
Emelkedett OR-t okozhat a masszív reticulocytosis vagy leptocytosis (6. kép) (ritkán májbetegségek vagy vashiány velejárója).
|
2. kép |

3. kép |
|
|
|
| Vissza az oldal elejére |
|
|
|
|
|
|